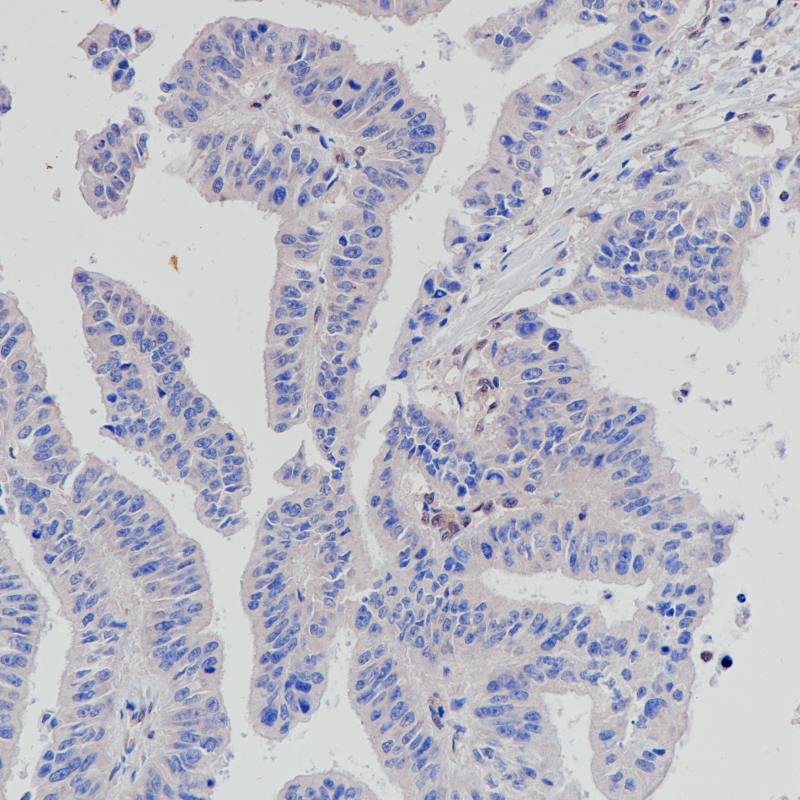
胰腺导管癌 肿瘤细胞缺失表达部位SMAD4(BP6219)染色

产品中心

胰腺导管癌 正常表达部位SMAD4(BP6219)染色
胰腺导管癌 肿瘤细胞缺失表达部位SMAD4(BP6219)染色
SMAD4 重组兔单克隆抗体
SMAD 4与SMAD1和YY1在骨形态发生蛋白(BMP)介导的心脏特异性基因表达中起协同作用。它是在细胞核中形成的异质三聚体SMAD2-SMAD3-SMAD4复合物的组成部分,是TGF介导的信号通路所必需的,并促进SMAD2/SMAD4/FAST-1复合物与DNA的结合。SMAD 4在大多数组织中呈细胞质和核表达。SMAD 4基因的改变最初是在胰腺癌(导管腺癌)中发现的,但也出现在各种癌症中,如结直肠癌、胃癌、前列腺癌、黑色素瘤、头颈部癌和许多其他癌症中。
Specifications
- 目录号
- BX50242
- 克隆号
- BP6219
- 阳性对照
- 胰腺导管癌
- 亚细胞定位
- 细胞核/细胞质
- 组织类型
- FFPE
- 修复方式
- HIER
- 稀释比
- 1:100-1:200
- 规格
- 100μl/vial, 1ml/vial
- 用途
- RUO


